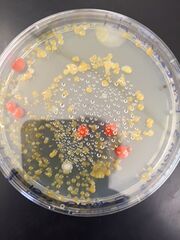
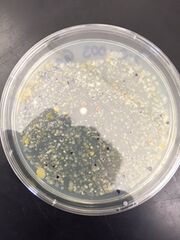

Uploads by Philip S. Sumberaz
From OpenWetWare
Jump to navigationJump to search
This special page shows all uploaded files.
| Date | Name | Thumbnail | Size | Description |
|---|---|---|---|---|
| 05:12, 19 February 2015 | Data Table Invertebrates.JPG (file) |  |
81 KB | |
| 05:11, 19 February 2015 | Springtails.JPG (file) |  |
54 KB | |
| 07:18, 12 February 2015 | Plant Life Chart.JPG (file) |  |
530 KB | |
| 05:41, 5 February 2015 | Hard Copy Observations.JPG (file) |  |
32 KB | |
| 05:40, 5 February 2015 | 10^-3 TET Plate.JPG (file) | |
38 KB | |
| 05:39, 5 February 2015 | 10^-3 Regular Plate.JPG (file) | |
35 KB | |
| 07:05, 29 January 2015 | Ameoba Proteus.jpg (file) |  |
72 KB | |
| 06:03, 26 January 2015 | Transect Map G5 S3.jpg (file) |  |
79 KB | |
| 05:55, 26 January 2015 | Transect Map.jpg (file) |  |
79 KB | |
| 05:54, 26 January 2015 | Transect Map 0351.jpg (file) |  |
79 KB |